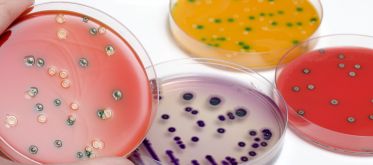

Tout savoir sur le programme conjoint européen (EJP) One Health
Après plus de cinq ans, le programme conjoint européen « One Health EJP » va bientôt se terminer. Coordonné par l’Anses, il a contribué à mettre en pratique le concept « One Health – Une seule santé » pour améliorer les connaissances dans la lutte contre les épidémies d'origine alimentaire en Europe. Dans ce dossier spécial, retrouvez en détail notre implication au sein de ce programme et les résultats des différents projets de recherche.
Le programme conjoint européen « One Health EJP » en bref
- Lien vers le site web de One Health EJP
- Une durée de plus de 5 ans, du 1er janvier 2018 au 30 septembre 2023.
- 44 partenaires de 22 pays européens : des organismes de recherche et des agences de sécurité sanitaire.
- Cofinancé par le programme cadre européen de recherche et d’innovation « Horizon 2020 » et par les partenaires.
- Préfiguré par le réseau d’excellence « MED-VET-NET », qui avait pour objectif de réunir au niveau européen des compétences en sciences vétérinaires, en santé publique et en sécurité sanitaire des aliments.
bleu_clair
Clôture du programme conjoint européen (EJP) One health

Le programme conjoint européen (EJP) One health prendra fin le 30 septembre 2023.A cette occasion, l'Anses, en tant que coordinateur organise la conférence finale du Programme.
Rapport final 2023 (EJP) One health (en anglais)
- Lire l'actualité

L'EJP One health fait partie de ces initiatives ayant fait collaborer avec succès des chercheurs en santé humaine, sécurité sanitaire des aliments et santé animale. Il a aussi contribué à sensibiliser les communautés à la nécessité de ne plus travailler en silo pour répondre aux défis sanitaires d’aujourd’hui et de demain."
- Lire l'interview d'Arnaud Callegari, coordinateur du One Health European Joint Programme (EJP).